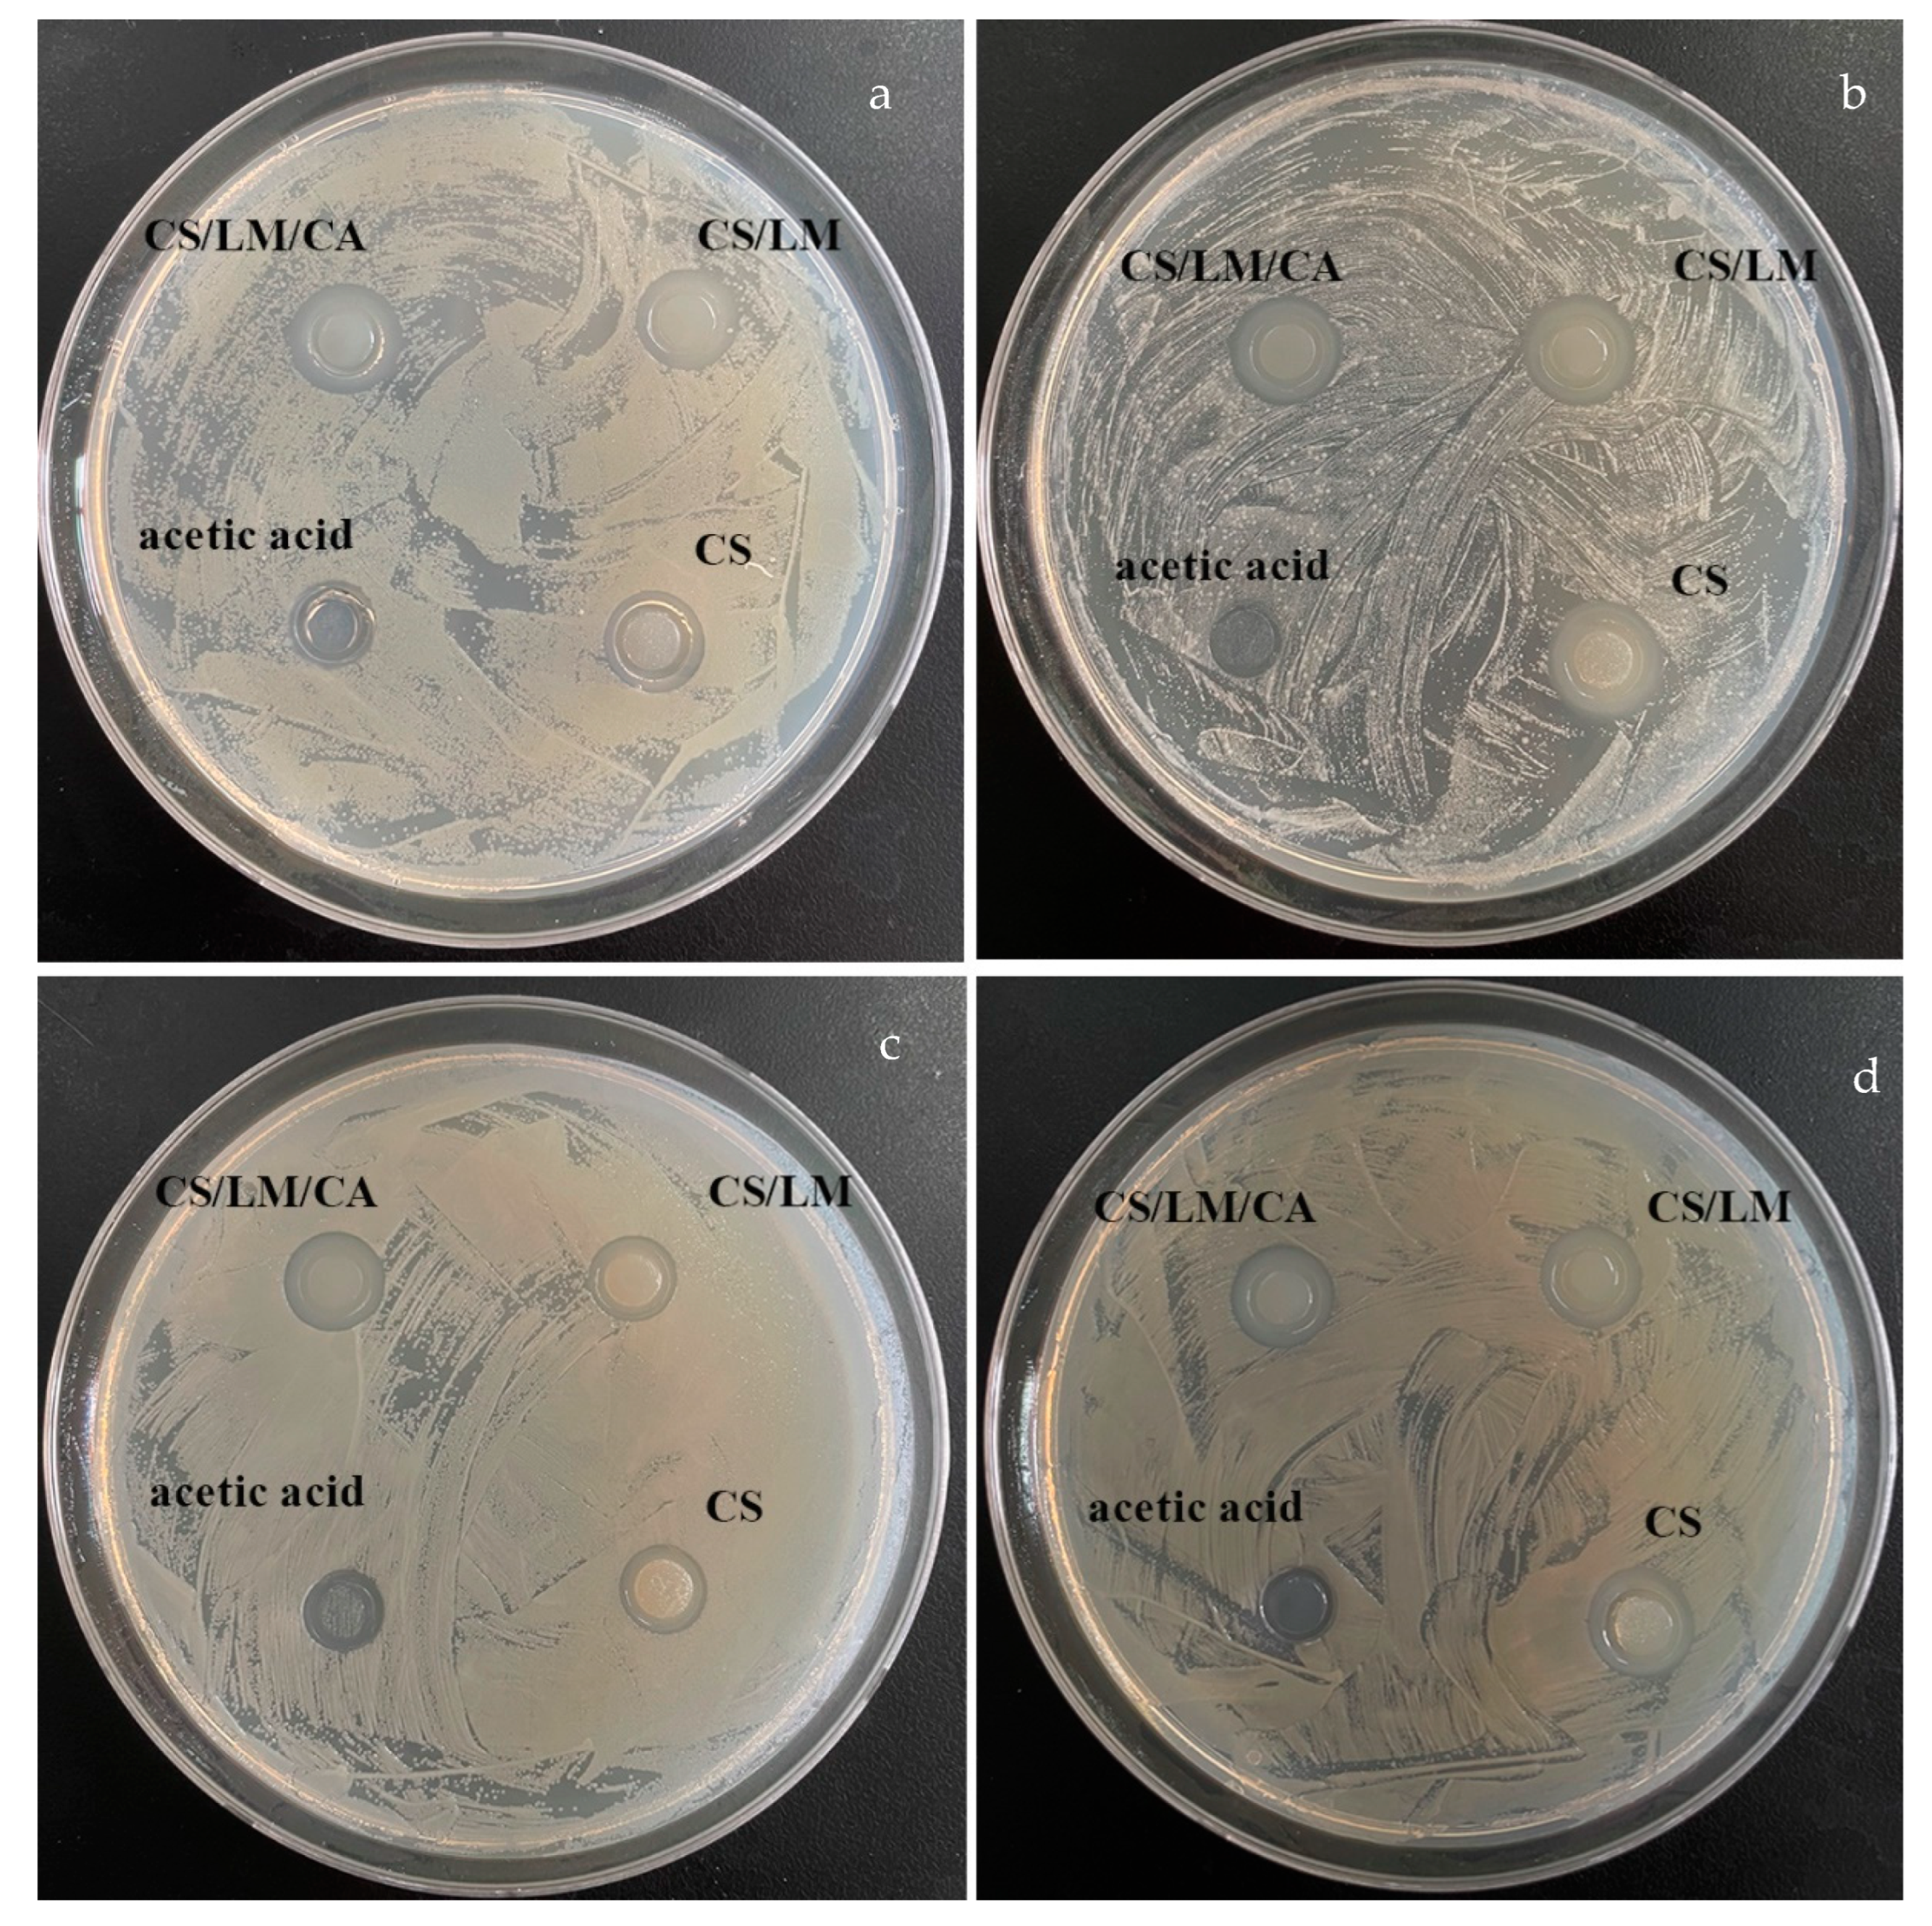
Foods 12 02642 g005

Preparation and Characterization of a Biodegradable Film Using Irradiated Chitosan Incorporated with Lysozyme and Carrageenan and Its Application in Crayfish Preservation
Abstract
1. Introduction
2. Materials and Methods
2.1. Materials
2.2. Irradiation Degradation of Chitosan
2.3. Preparation of Films
2.4. Experiment Design
2.5. Thickness and Mechanical Properties of the Films
2.6. Morphology and Color of the Films
2.7. Water Vapor Transmission Rate (WVTR) and Oxygen Permeability
2.8. Water Contact Angle
2.9. Opacity (OP)
2.10. FTIR
2.11. XRD
2.12. SEM
2.13. Antibacterial Activity of CS, CS/LM, and CS/LM/SA
2.14. Preservation Effect of Crayfish by Different Films
2.14.1. Sample Preparation
2.14.2. Determination of Total Volatile Basic Nitrogen (TVB-N) and Total Aerobic Micro-organisms
2.14.3. pH Analysis
2.14.4. Thiobarbituric Acid Reactive Substance (TBARS) Assay
2.14.5. Texture Profile Analysis (TPA)
2.15. Statistical Analysis
3. Results and Discussion
3.1. Irradiation of Chitosan
3.2. Response Surface Experiment
3.3. Tensile Strength and Elongation Break of Different Films
3.4. Physical Characteristics of Different Composite Films
3.5. Color Analysis
3.6. Opacity
3.7. Water Contact Angle
3.8. FTIR Analysis
3.9. XRD Analysis
3.10. SEM Analysis
3.11. Antibacterial Activity
3.12. Quality Changes in Crayfish Meat during Storage
3.12.1. TVB-N and Total Aerobic Micro-Organisms
3.12.2. pH
3.12.3. TBARS Assay
3.12.4. Texture Profile Analysis
4. Conclusions
Supplementary Materials
Author Contributions
Funding
Data Availability Statement
Conflicts of Interest
References
- Odeyemi, O.A.; Alegbeleye, O.O.; Strateva, M.; Stratev, D. Understanding spoilage microbial community and spoilage mechanisms in foods of animal origin. Compr. Rev. Food Sci. Food Saf. 2020, 19, 311–331. [Google Scholar] [CrossRef]
- Sun, X.; Wang, J.; Dong, M.; Zhang, H.; Li, L.; Wang, L. Food spoilage, bioactive food fresh-keeping films and functional edible coatings: Research status, existing problems and development trend. Trends Food Sci. Technol. 2022, 119, 122–132. [Google Scholar] [CrossRef]
- Wang, M.; Bi, S.; Qin, D.; Su, C.; Wang, H.; Chen, X. Quantitative evaluation of the antibacterial effectiveness and efficiency of chitosan considering the effect of neutralization. Carbohydr. Polym. 2021, 265, 141–161. [Google Scholar] [CrossRef]
- Liu, J.; Li, K.; Chen, Y.; Ding, H.; Wu, H.; Gao, Y.; Huang, S.; Wu, H.; Kong, D.; Yang, Z.; et al. Active and smart biomass film containing cinnamon oil and curcumin for meat preservation and freshness indicator. Food Hydrocoll. 2022, 133, 107979. [Google Scholar] [CrossRef]
- Shen, B.; Sun, S.; Zhu, L.; Yu, J.; Jiang, L. Intelligent Bio-FeS-loaded chitosan films with H2O2 rapid response for advanced waterproof and antibacterial food packaging. Food Packag. Shelf Life 2023, 37, 130–141. [Google Scholar] [CrossRef]
- Huong, Q.T.T.; Nam, N.T.H.; Duy, B.T.; An, H.; Hai, N.D.; Ngan, H.T.K.; Ngan, L.T.; Nhi, T.L.H.; Linh, D.T.Y.; Khanh, T.N. Structurally natural chitosan films decorated with Andrographis paniculata extract and selenium nanoparticles: Properties and strawberry preservation. Food Biosci. 2023, 53, 102647. [Google Scholar] [CrossRef]
- Yan, Y.; Duan, S.; Zhang, H.; Liu, Y.; Li, C.; Hu, B.; Liu, A.; Wu, D.; He, J.; Wu, W. Preparation and characterization of Konjac glucomannan and pullulan composite films for strawberry preservation. Carbohydr. Polym. 2020, 243, 426–446. [Google Scholar] [CrossRef]
- Zheng, M.; Chen, J.; Tan, K.B.; Chen, M.; Zhu, Y. Development of hydroxypropyl methylcellulose film with xanthan gum and its application as an excellent food packaging bio-material in enhancing the shelf life of banana. Food Chem. 2022, 4, 374–389. [Google Scholar] [CrossRef] [PubMed]
- Zhang, Y.P.; Wang, X.; Shen, Y.; Thakur, K.; Zhang, J.G.; Hu, F.; Wei, Z.J. Preparation and Characterization of Bio-Nanocomposites Film of Chitosan and Montmorillonite Incorporated with Ginger Essential Oil and Its Application in Chilled Beef Preservation. Antibiotics 2021, 10, 796. [Google Scholar] [CrossRef] [PubMed]
- Luo, J.; Gu, Y.; Yuan, Y.; Wu, W.; Jin, Y.; Jiang, B. Lignin-induced sacrificial conjoined-network enabled strong and tough chitosan membrane for food preservation. Carbohydr. Polym. 2023, 313, 50–61. [Google Scholar] [CrossRef] [PubMed]
- Aranaz, I.; Alcántara, A.R.; Civera, M.C.; Arias, C.; Elorza, B.; Heras Caballero, A.; Acosta, N. Chitosan: An Overview of Its Properties and Applications. Polymers 2021, 13, 3256. [Google Scholar] [CrossRef]
- Sikorski, D.; Bauer, M.; Frączyk, J.; Draczyński, Z. Antibacterial and Antifungal Properties of Modified Chitosan Nonwovens. Polymers 2022, 14, 1690. [Google Scholar] [CrossRef] [PubMed]
- Gomes, L.P.; Souza, H.K.; Campiña, J.M.; Andrade, C.T.; Paschoalin, V.M.F.; Silva, A.F.; Gonçalves, M.P. Tweaking the mechanical and structural properties of colloidal chitosans by sonication. Food Hydrocoll. 2016, 56, 29–40. [Google Scholar] [CrossRef]
- Choi, W.S.; Ahn, K.J.; Lee, D.W.; Byun, M.W.; Park, H.J. Preparation of chitosan oligomers by irradiation. Polym. Degrad. Stab. 2002, 78, 533–538. [Google Scholar] [CrossRef]
- Kwaśniewska, A.; Chocyk, D.; Gładyszewski, G.; Borc, J.; Świetlicki, M.; Gładyszewska, B. The Influence of Kaolin Clay on the Mechanical Properties and Structure of Thermoplastic Starch Films. Polymers 2020, 12, 73. [Google Scholar] [CrossRef] [PubMed]
- Aaliya, B.; Sunooj, K.V.; Lackner, M. Biopolymer composites: A review. Int. J. Biobased Plast. 2021, 3, 40–84. [Google Scholar] [CrossRef]
- Marand, S.A.; Almasi, H.; Marand, N.A. Chitosan-based nanocomposite films incorporated with NiO nanoparticles: Physicochemical, photocatalytic and antimicrobial properties. Int. J. Biol. Macromol. 2021, 190, 667–678. [Google Scholar] [CrossRef]
- Elsawy, M.A.; Fekry, M.; Sayed, A.M.; Maziad, N.A.; Saad, G.R. Physico-chemical Characteristics of Biodegradable Poly(lactic acid) and Poly(lactic acid)/Chitosan Nano-Composites Under the Influence of Gamma Irradiation. J. Polym. Environ. 2023, 31, 2705–2714. [Google Scholar] [CrossRef]
- Rahman, M.M.; Kabir, S.; Rashid, T.U.; Nesa, B.; Nasrin, R.; Haque, P.; Khan, M.A. Effect of γ-irradiation on the thermomechanical and morphological properties of chitosan obtained from prawn shell: Evaluation of potential for irradiated chitosan as plant growth stimulator for Malabar spinach. Radiat. Phys. Chem. 2013, 82, 112–118. [Google Scholar] [CrossRef]
- Kunhanna, S.B.; Patil, V.B.; Sesappa, D.B. Studies on characterization of blue emissive chitosan/carbazolyl biphenyl (CRB) composite films and their gamma ray irradiation mediated fluorescence quenching phenomenon. Opt. Mater. 2023, 138, 112–118. [Google Scholar]
- Si, J.; Yang, Y.; Xing, X.; Yang, F.; Shan, P. Controlled degradable chitosan/collagen composite scaffolds for application in nerve tissue regeneration. Polym. Degrad. Stab. 2019, 16, 73–85. [Google Scholar] [CrossRef]
- Li, L.; Liu, W.; Yao, X.; Wang, W.; Yan, C.; Kang, D. Study on film forming characteristic of ε-polylysine grafted chitosan through TEMPO oxidation system and its preservation effects for pork fillet. Meat Sci. 2023, 210, 109–118. [Google Scholar] [CrossRef]
- Cao, S.; Wang, S.; Wang, Q.; Lin, G.; Niu, B.; Guo, R.; Yan, H.; Wang, H. Sodium alginate/chitosan-based intelligent bilayer film with antimicrobial activity for pork preservation and freshness monitoring. Food Control 2023, 148, 219–228. [Google Scholar] [CrossRef]
- Alizadeh-Sani, M.; Tavassoli, M.; Mohammadian, E.; Ehsani, A.; Khaniki, G.J.; Priyadarshi, R.; Rhim, J.W. pH-responsive color indicator films based on methylcellulose/chitosan nanofiber and barberry anthocyanins for real-time monitoring of meat freshness. Int. J. Biol. Macromol. 2020, 166, 741–750. [Google Scholar] [CrossRef]
- Aloui, H.; Deshmukh, A.R.; Khomlaem, C.; Kim, B.S. Novel composite films based on sodium alginate and gallnut extract with enhanced antioxidant, antimicrobial, barrier and mechanical properties. Food Hydrocoll. 2021, 113, 106508. [Google Scholar] [CrossRef]
- Bao, Y.; Cui, H.; Tian, J.; Ding, Y.; Tian, Q.; Zhang, W.; Wang, M.; Zang, Z.; Sun, X.; Li, D.; et al. Novel pH sensitivity and colorimetry-enhanced anthocyanin indicator films by chondroitin sulfate co-pigmentation for shrimp freshness monitoring. Food Control 2022, 131, 108441. [Google Scholar] [CrossRef]
- Chong, J.X.; Lai, S.; Yang, H. Chitosan combined with calcium chloride impacts fresh-cut honeydew melon by stabilising nanostructures of sodium-carbonate-soluble pectin. Food Control 2015, 53, 195–205. [Google Scholar] [CrossRef]
- Chan, M.Y.; Koay, S.C. Biodegradation and thermal properties of crosslinked chitosan/corn cob biocomposite films by electron beam irradiation. Polym. Eng. Sci. 2018, 59, E59–E68. [Google Scholar] [CrossRef]
- ASTM D882; Standard Test Method for Tensile Properties of Thin Plastic Sheeting. Astm Standards: West Conshohocken, PA, USA, 2018; p. 12.
- Mouzahim, M.E.; Eddarai, E.M.; Eladaoui, S.; Guenbour, A.; Bellaouchou, A.; Zarrouk, A.; Boussen, R. Effect of Kaolin clay and Ficus carica mediated silver nanoparticles on chitosan food packaging film for fresh apple slice prese. Food Chem. 2023, 410, 135470. [Google Scholar] [CrossRef] [PubMed]
- Odjo, K.; Al-Maqtari, Q.A.; Yu, H.; Xie, Y.; Guo, Y.; Li, M.; Du, Y.; Liu, K.; Chen, Y.; Yao, W. Preparation and characterization of chitosan-based antimicrobial films containing encapsulated lemon essential oil by ionic gelation and cranberry juice. Food Chem. 2022, 397, 133781. [Google Scholar] [CrossRef] [PubMed]
- Wang, Y.; Tang, J.; Zeng, Y.; Liu, X.; Chen, M.; Dai, J.; Li, S.; Qin, W.; Liu, Y. Nanofibrous composite membranes based on chitosan-nano zinc oxide and curcumin for Kyoho grapes preservation. Int. J. Biol. Macromol. 2023, 242, 178–190. [Google Scholar] [CrossRef]
- Kraisit, P.; Luangtana-Anan, M.; Sarisuta, N. Effect of Various Types of Hydroxypropyl Methylcellulose (HPMC) Films on Surface Free Energy and Contact Angle. Adv. Mater. Res. 2015, 1060, 107–110. [Google Scholar]
- Lu, S.; Tao, J.; Liu, X.; Wen, Z. Baicalin-liposomes loaded polyvinyl alcohol-chitosan electrospinning nanofibrous films: Characterization, antibacterial properties and preservation effects on mushrooms. Food Chem. 2022, 371, 131372. [Google Scholar] [CrossRef]
- Chen, M.; Yan, X.; Cheng, M.; Zhao, P.; Wang, Y.; Zhang, R.; Wang, X.; Wang, J.; Chen, M. Preparation, characterization and application of poly(lactic acid)/corn starch/eucalyptus leaf essential oil microencapsulated active bilayer degradable film. Int. J. Biol. Macromol. 2022, 195, 264–273. [Google Scholar] [CrossRef]
- Qiu, L.; Ma, H.; Luo, Q.; Bai, C.; Xiong, G.; Jin, S.; Wang, J.; Zu, X.; Li, H.; Liao, T. Preparation, Characterization, and Application of Modified Starch/Chitosan/Sweet Orange Oil Microcapsules. Foods 2022, 11, 2306. [Google Scholar] [CrossRef]
- Pissia, M.-A.; Matsakidou, A.; Paraskevopoulou, A.; Kiosseoglou, V. Structural characteristics and physicochemical properties of freeze-dried snail meat. LWT 2022, 155, 112980. [Google Scholar] [CrossRef]
- Kalia, S.; Salim, A.; Bala, R.; Singh, R.K.; Singhal, R.; Dhiman, R. Energy Ag ion irradiation-induced surface modification studies of Au-graphene oxide nanocomposite thin films. Thin Solid Film. 2023, 772, 139–148. [Google Scholar] [CrossRef]
- Matsuhashi, S.; Kume, T. Enhancement of Antimicrobial Activity of Chitosan by Irradiation. J. Sci. Food Agric. 1997, 73, 237–241. [Google Scholar] [CrossRef]
- Buatong, J.; Mittal, A.; Mittraparp-Arthorn, P.; Palamae, S.; Saetang, J.; Benjakul, S. Bactericidal Action of Shrimp Shell Chitooligosaccharide Conjugated with Epigallocatechin Gallate (COS-EGCG) against Listeria monocytogenes. Foods 2023, 12, 634. [Google Scholar] [CrossRef] [PubMed]
- Yang, Z.; Yang, Y.; Zhang, X.; Fu, B.; Xu, W.; Xue, D.; Chen, N.; Wang, X.; Xie, Q. Construction of sodium alginate/konjac glucomannan/chitosan oligosaccharide/Zeolite P hydrogel microspheres loaded with potassium diformate for sustained intestinal bacterial inhibition. Eur. Polym. J. 2022, 172, 34–51. [Google Scholar] [CrossRef]
- Wang, W.; Wang, Q.; Chen, X.; Kong, Y.; Wu, M.; Zhu, S.; Chen, M.; Li, L. Release kinetics of pectin/eugenol composite film and application in pork preservation. Appl. Polym. 2023, 14, 536–549. [Google Scholar] [CrossRef]
- Luo, Q.; Huang, X.; Luo, Y.; Yuan, H.; Ren, T.; Li, X.; Xu, D.; Guo, X.; Wu, Y. Fluorescent chitosan-based hydrogel incorporating titanate and cellulose nanofibers modified with carbon dots for adsorption and detection of Cr(VI). Chem. Eng. J. 2020, 407, 127050. [Google Scholar] [CrossRef]
- El-Fawal, G. Preparation, characterization and antibacterial activity of biodegradable films prepared from carrageenan. J. Food Sci. Technol. 2014, 51, 2234–2239. [Google Scholar] [CrossRef] [PubMed]
- Erna, K.H.; Felicia WX, L.; Vonnie, J.M.; Rovina, K.; Yin, K.W.; Nur’Aqilah, M.N. Synthesis and physicochemical characterization of polymer film-based anthocyanin and starch. Biosensors 2022, 12, 211. [Google Scholar] [CrossRef] [PubMed]
- Cui, F.; Xi, L.; Wang, D.; Tan, X.; Li, J.; Li, T. High-Release, Residue-Free Polysaccharide Hydrogel for Refrigerated Food Preservation. ACS Appl. Mater. Interface 2023, 15, 6035–6046. [Google Scholar] [CrossRef]
- Park, S.-I.; Daeschel, M.; Zhao, Y. Functional Properties of Antimicrobial Lysozyme-Chitosan Composite Films. J. Food Sci. 2004, 69, 215–221. [Google Scholar] [CrossRef]
- Xia, G.; Jia, R.; Tong, J.; Zhang, X.; Zhang, S.; Wei, H.; Yang, W. Cryoprotective Effects of Carrageenan on Pre-prepared Gel of Minced Shrimp (Litopenaeus Vannamei) During Frozen Storage. Food Bioprocess Technol. 2023, 5, 124–133. [Google Scholar] [CrossRef]
- Liu, J.; Liu, S.; Wu, Q.; Gu, Y.; Kan, J.; Jin, C. Effect of protocatechuic acid incorporation on the physical, mechanical, structural and antioxidant properties of chitosan film. Food Hydrocoll. 2017, 73, 90–100. [Google Scholar] [CrossRef]
- Zhang, W.; Jiang, W. Antioxidant and antibacterial chitosan film with tea polyphenols-mediated green synthesis silver nanoparticle via a novel one-pot method. Int. J. Biol. Macromol. 2019, 12, 94–109. [Google Scholar] [CrossRef]
- Ceballos, R.L.; Von Bilderling, C.; Guz, L.; Bernal, C.; Famá, L. Effect of greenly synthetized silver nanoparticles on the properties of active starch films obtained by extrusion and compression molding. Carbohydr. Polym. 2021, 14, 261–279. [Google Scholar] [CrossRef]
- Ediyilyam, S.; George, B.; Shankar, S.S.; Dennis, T.T.; Wacławek, S.; Černík, M.; Padil, V.V.T. Chitosan/gelatin/silver nanoparticles composites films for biodegradable food packaging applications. Polymers 2021, 13, 1680. [Google Scholar] [CrossRef]
- Mohamed, N.; Madian, N.G. Evaluation of the mechanical, physical and antimicrobial properties of chitosan thin films doped with greenly synthesized silver nanoparticles. Mater. Today Commun. 2020, 25, 101372. [Google Scholar] [CrossRef]
- Butnaru, E.; Stoleru, E.; Brebu, M.A.; Darie-Nita, R.N.; Bargan, A.; Vasile, C. Chitosan-Based Bionanocomposite Films Prepared by Emulsion Technique for Food Preservation. Materials 2019, 12, 373. [Google Scholar] [CrossRef]
- Vinodhini, P.A.; Sangeetha, K.; Thandapani, G.; Sudha, P.N.; Jayachandran, V.; Sukumaran, A. FTIR, XRD and DSC studies of nanochitosan, cellulose acetate and polyethylene glycol blend ultrafiltration membranes. Int. J. Biol. Macromol. 2017, 104, 1721–1729. [Google Scholar] [CrossRef] [PubMed]
- Rambabu, K.; Bharath, G.; Banat, F.; Show, P.L.; Cocoletzi, H.H. Mango leaf extract incorporated chitosan antioxidant film for active food packaging—ScienceDirect. Int. J. Biol. Macromol. 2019, 126, 1234–1243. [Google Scholar]
- Wang, H.; Ding, F.; Ma, L.; Zhang, Y. Edible films from chitosan-gelatin: Physical properties and food packaging application. Food Biosci. 2021, 40, 100871. [Google Scholar] [CrossRef]
- Qi, Z.; Xie, P.; Yang, C.; Xue, X.; Chen, H.; Zhou, H.; Yuan, H.; Yang, G.; Wang, C. Developing fisetin-AgNPs incorporated in reinforced chitosan/pullulan composite-film and its application of postharvest storage in litchi fruit. Food Chem. 2023, 407, 135122. [Google Scholar] [CrossRef]
- Xiong, Z.; Sun, D.W.; Pu, H.; Xie, A.; Han, Z.; Luo, M. Non-destructive prediction of thiobarbituricacid reactive substances (TBARS) value for freshness evaluation of chicken meat using hyperspectral imaging. Food Chem. 2015, 179, 175–181. [Google Scholar] [CrossRef]
- Bertolo, M.R.; Martins, V.C.; Horn, M.M.; Brenelli, L.B.; Plepis, A.M. Rheological and antioxidant properties of chitosan/gelatin-based materials functionalized by pomegranate peel extract. Carbohydr. Polym. 2020, 228, 115386. [Google Scholar] [CrossRef] [PubMed]
- Hu, L.; Ying, Y.; Zhang, H.; Liu, J.; Chen, X.; Shen, N.; Li, Y.; Hu, Y. Advantages of liquid nitrogen freezing in long-term frozen preservation of hairtail (Trichiurus haumela): Enzyme activity, protein structure, and tissue structure. J. Food Process Eng. 2021, 21, 134–149. [Google Scholar] [CrossRef]
- Fang, C.; Chen, H.; Yan, H.; Shui, S.; Benjakul, S.; Zhang, B. Investigation of the changes in the lipid profiles in hairtail (Trichiurus haumela) muscle during frozen storage using chemical and LC/MS-based lipidomics analysis. Food Chem. 2022, 390, 133140. [Google Scholar] [CrossRef] [PubMed]
- Wu, T.; Li, Y.; Shen, N.; Yuan, C.; Hu, Y. Preparation and characterization of calcium alginate-chitosan complexes loaded with lysozyme. J. Food Eng. 2018, 233, 109–116. [Google Scholar] [CrossRef]
- Lin, Y.; Qiao, C.; Zhao, Z.; Xia, Y.; Zhao, G.; Xue, Z. Fabrication and Characterization of Carrageenan/ZnO/Chitosan Composite Films. Langmir 2023, 39, 7930–7938. [Google Scholar] [CrossRef] [PubMed]

| Material | Concentration (g/mL) | ||||
|---|---|---|---|---|---|
| CS | 0.001 | 0.015 | 0.02 | 0.025 | 0.03 |
| LM | 0.001 | 0.0015 | 0.002 | 0.0025 | 0.003 |
| CA | 0.0005 | 0.001 | 0.0015 | 0.002 | 0.0025 |
| Irradiation Dose | 0 KGy | 20 KGy | 40 KGy | 60 KGy | 80 KGy | 100 KGy |
|---|---|---|---|---|---|---|
| Intrinsic viscosity | 380 | 237 | 127 | 115 | 111 | 110 |
| molecular weight | 591,862 | 329,097 | 151,527 | 133,937 | 128,170 | 126,736 |
| Content | Thickness (mm) | TS (N) | EB (%) | WVTR (g·mm/m2·h·Pa) | Oxygen Permeability (m3·µm/m2·day·kPa) |
|---|---|---|---|---|---|
| CS | 0.077 ± 0.004 b | 16.87 ± 0.78 b | 3.83 ± 0.01 b | 5.83 ± 0.39 a | 31.66 ± 0.94 b |
| CS/LM | 0.078 ± 0.001 b | 17.46 ± 0.64 b | 4.35 ± 0.08 b | 5.74 ± 0.14 a | 30.14 ± 0.98 b |
| CS/LM/CA | 0.112 ± 0.002 a | 20.28 ± 0.18 a | 6 ± 0.32 a | 4.75 ± 0.11 b | 24.31 ± 0.81 a |
| Films | ΔE | L | a | b | W | OP (mm−1) |
|---|---|---|---|---|---|---|
| CS | 8.73 ± 0.49 b | −2.67 ± 0.38 a | −0.37 ± 0.06 a | 8.30 ± 0.44 b | −3.01 ± 0.41 a | 4.85 ± 0.29 b |
| CS/LM | 9.23 ± 0.41 b | −2.83 ± 0.32 b | −0.43 ± 0.05 a | 8.80 ± 0.36 b | −3.21 ± 0.35 b | 4.7 ± 0.19 b |
| CS/LM/CA | 18.5 ± 0.52 a | −6.53 ± 0.25 a | 0.60 ± 0.26 b | 17.27 ± 0.49 a | −7.93 ± 0.31 b | 8.59 ± 0.25 a |
| Bacterial Strains | Zone of Inhibition (mm) | |||
|---|---|---|---|---|
| 1% Acetic | CS | CS/LM | CS/LM/CA | |
| Salmonella typhimurium | 8.37 ± 0.24 a | 10.04 ± 0.13 b | 13.74 ± 0.12 ab | 14.25 ± 0.66 a |
| Shewanella putrefaciens | 7.59 ± 0.30 b | 9.97 ± 0.29 a | 14.32 ± 0.31 a | 14.78 ± 0.21 a |
| Staphylococcus aureus | 8.34 ± 0.15 a | 11.18 ± 0.76 b | 14.19 ± 0.85 b | 16.37 ± 0.12 a |
| Escherichia coli | 8.21 ± 0.12 a | 10.36 ± 0.12 ab | 12.01 ± 0.59 ab | 14.49 ± 0.11 a |
Disclaimer/Publisher’s Note: The statements, opinions and data contained in all publications are solely those of the individual author(s) and contributor(s) and not of MDPI and/or the editor(s). MDPI and/or the editor(s) disclaim responsibility for any injury to people or property resulting from any ideas, methods, instructions or products referred to in the content. |
© 2023 by the authors. Licensee MDPI, Basel, Switzerland. This article is an open access article distributed under the terms and conditions of the Creative Commons Attribution (CC BY) license (https://creativecommons.org/licenses/by/4.0/).
Share and Cite
Qiu, L.; Luo, Q.; Bai, C.; Xiong, G.; Jin, S.; Li, H.; Liao, T. Preparation and Characterization of a Biodegradable Film Using Irradiated Chitosan Incorporated with Lysozyme and Carrageenan and Its Application in Crayfish Preservation. Foods 2023, 12, 2642. https://doi.org/10.3390/foods12142642
Qiu L, Luo Q, Bai C, Xiong G, Jin S, Li H, Liao T. Preparation and Characterization of a Biodegradable Film Using Irradiated Chitosan Incorporated with Lysozyme and Carrageenan and Its Application in Crayfish Preservation. Foods. 2023; 12(14):2642. https://doi.org/10.3390/foods12142642
Chicago/Turabian StyleQiu, Liang, Qinghua Luo, Chan Bai, Guangquan Xiong, Shiwei Jin, Hailan Li, and Tao Liao. 2023. "Preparation and Characterization of a Biodegradable Film Using Irradiated Chitosan Incorporated with Lysozyme and Carrageenan and Its Application in Crayfish Preservation" Foods 12, no. 14: 2642. https://doi.org/10.3390/foods12142642
APA StyleQiu, L., Luo, Q., Bai, C., Xiong, G., Jin, S., Li, H., & Liao, T. (2023). Preparation and Characterization of a Biodegradable Film Using Irradiated Chitosan Incorporated with Lysozyme and Carrageenan and Its Application in Crayfish Preservation. Foods, 12(14), 2642. https://doi.org/10.3390/foods12142642
